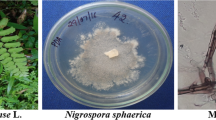

Abstract
The present investigation has been performed for the isolation, optimization, and chemical characterization of antibacterial compounds from endophytic fungi that survive inside the internal tissues of plants without causing any symptoms. Endophytic fungi were isolated from four medicinal plants and screened for their antibacterial activity. The fungal strain Phoma sp. D1 showed maximum antibacterial activity at 18.25 ± 0.58, 22.75 ± 0.85, 19.30 ± 0.76, and 16.30 ± 0.65 against Klebsiella pneumoniae, Bacillus subtilis, Escherichia coli, and Staphylococcus aureus, respectively. For maximum production of antibacterial compounds, Phoma sp. D1 was further optimized on different sources such as culture media, pH, temperature, carbon and nitrogen sources, and incubation period. The optimum culture media, pH, temperature, carbon and nitrogen, and incubation period for bioactive metabolite production of the strain were recorded in SDB, dextrose, yeast extract, 25 ± 0.1, and pH 8.0. The purification and chemical characterization of the antibacterial compounds were done by using solvent–solvent extraction, thin-layer chromatography, and gas chromatography and mass spectroscopy. The chemical characterization of the extract from Phoma sp. D1 showed the presence of five compounds, 2-(-cyclohexenyl) ethylamine, 2-chloro-6 fluorophenol, butyl ether2-hydroxyskatole4-glycerol, p-coumarate, and bicyclo [4,2,1] nona-2,4-dien-9-one could be responsible for antibacterial activity. The computation observation of biomolecules through DFT, QSAR, EHOMO, and ELUMO was also performed.
Similar content being viewed by others
Avoid common mistakes on your manuscript.
Introduction
India has been considered to be a rich repository of medicinal plants which have been widely collected as raw materials for the manufacture of useful products since time immemorial. According to a recent World Health Organization (WHO) assessment, 80% of people worldwide rely on natural herbs for their basic medical needs [1, 2]. In developed nations, for example, the USA, plant based constitutes as much as 25% of the all-out medications while in fast-developing nations such as India and China, the commitment of characteristic assets for the readiness of medication is as much as 80% [3]. However, the uncontrolled exploitation of medicinal plants has resulted in a rapid decline in their populations, and some of the plants have become critically endangered. The manufacturing of plant-based medicines has increased with the population, resulting in an overuse of plants and significant loss of plant diversity. Yet symbiotic microorganisms that thrive inside plant cells also contribute to the bioactive compounds that plants manufacture. In order to maintain plant diversity and improve the production of bioactive substances for the treatment of various diseases, much effort is being done in the field of endophytes [4,5,6,7,8].
Endophytes are microorganisms that live inside the tissues of living plants without causing any overt negative effect and have been found in each plant species considered and perceived as a potential source of novel natural products for exploitation in medicine, agriculture, and industry [9]. Endophytic microorganisms are endosymbiotic groups of organisms whether bacteria or fungi that colonize intercellular or intracellular locations of plant species [10]. The endophytic parasites upgrade the development and supplement gain of host life forms and improve the host capacity to endure different sorts of abiotic and biotic stresses and develop resistance in plants against insects and pests. They additionally produce phytohormones and other few bioactive substances such as proteins and drugs of biotechnological interest [11, 12]. The endophytic fungi are known to possess biosynthetic capabilities greater than those of host plants due to their long co-evolution and genetic recombination [13, 14].
In the previous 20 years, numerous important bioactive compounds with anti-microbial, insecticidal, cytotoxic and anticancer, antioxidant, antimalarial, antiviral, immune-suppressive, anti-tuberculosis, etc. activities have been successfully isolated from the endophytic fungi [15,16,17]. Further, theoretical and computational approaches such as DFT, QSAR, highest occupied molecular orbitals (HOMOs), and lowest unoccupied molecular orbital’s (LUMOs) help to identify the orientation of the molecules and the interaction of the molecules with active sites of the targets [18]. As a result, the primary goal of this research was to separate novel antibacterial compounds of pharmaceutical interest from endophytic fungi for use in the development of antibacterial medications to combat pathogenic and resistant bacteria.
Methods
Collection and Isolation of Endophytic Fungi
In the present study, endophytic fungi were isolated from different parts of medicinal plants, i.e., stems, leaves, and roots of Calotropis procera, Ocimum basilicum, Bryophyllum pinnatum, and Colocasia esculent collected from Jabalpur regions (M.P.). The explants were cleaned with tap water to remove the dust and debris from the outer surface of the samples and cut into 2–4-mm-sized pieces. Surface disinfection was carried out by dipping the plant parts into sterilized distilled water for up to 1–2 min and after that transferring them into 70% alcohol for 30 s, and then keeping them in 4% sodium hypochlorite (NaOCl) solution for 1–2 min [19,20,21]. Finally, the plant material was placed in distilled water for 1–2 min and transferred onto filter paper for removal of excess moisture from the samples. After surface disinfection, all plant parts were placed on potato dextrose agar (PDA) plates supplemented with streptomycin 500 mL/L to inhibit bacterial growth [22, 23]. All PDA plates were incubated in a fungal incubator for 3–5 days at 26 ± 1 °C, and regular growth of the hyphae was observed.
Preservation and Morphological Identification of Endophytic Fungi
All endophytic fungi isolated from different plant parts were maintained on PDA medium (potato: 200 g; dextrose: 20 g; agar: 15 g, and distilled water: 1000 mL) slants and preserved at 4–5 °C with proper labeling without antibiotics and subcultured at time to time. Morphological identification was done using the slide culture technique on the basis of various characteristics like the shape of the spores, growth and color of the cultured fungal colonies, structure of the hyphae, and size of the spore fungi [24, 25].
Production and Screening of Secondary Metabolites
For the production of secondary metabolites, the endophytic fungi were grown on potato dextrose broth (PDB) medium (potato: 200 g; dextrose: 20 g, and distilled water: 1000 mL) and incubated at 26 ± 1 °C for 7, 14, and 21 days, respectively [26, 27]. After the incubation period, the metabolites were separated by using Whatman filter paper no. 1; their antibacterial activity against test bacterial strains Klebsiella pneumoniae (MTCC4032), Bacillus subtilis (MTCC441), Escherichia coli (MTCC1679), and Staphylococcus aureus (MTCC96) was observed by using the agar well diffusion method, and the zone of inhibition was measured with the help of the Hi-Antibiotic zone scale, Hi Media Laboratories, Mumbai [28].
Optimization of Parameters for Maximum Production of Bioactive Compounds
For maximum production of bioactive compounds from potent endophytic fungi, various physical and chemical factors like incubation period, carbon and nitrogen sources, temperature, pH, and growth medium were examined.
Determination of Optimum Culture Medium
To assess optimum growth and maximum production of antibacterial compounds, the potent fungal strain Phoma sp. D1 was tested on different media viz. potato dextrose broth (PDB) medium (potato: 200 g, dextrose: 20 g, and distilled water: 1000 mL), Sabouraud dextrose broth (SDB) medium (dextrose: 40 g, peptone: 10 g, and distilled water: 1000 mL), maltose yeast extract broth (MYEB) medium (maltose: 4 g, yeast extract: 4 g, malt extract: 10 g, and distilled water: 1000 mL), Czapek Dox broth (CDB) medium (sodium nitrate: 2 g, dipotassium hydrogen phosphate: 1 g, magnesium sulfate: 0.5 g, potassium chloride: 0.5 g, ferrous sulfate: 0.01 g, sucrose: 30 g, and distilled water: 1000 mL), and Richard broth medium (dipotassium dihydrogen phosphate: 5 g, magnesium sulfate: 2.5 g, potassium nitrate: 10 g, ferric chloride: 0.02 g, sucrose: 50 g, and distilled water: 1000 mL). After 7, 14, and 21 days, the antibacterial activity of the selected media was observed by using the agar well diffusion method [29].
Determination of Optimum Incubation Period
Phoma sp. D1 was used in the steady incubation process for 21 days on a selected medium at 25 ± 1 °C. The cell-free culture filtrate (CFCF) of fungi was extracted from the first day of incubation, and the antibacterial activity was observed by using the agar well diffusion method [30].
Determination of Optimum Nitrogen and Carbon Sources
To determine the effect of carbon and nitrogen sources on the production of secondary metabolites, various carbon and nitrogen sources like maltose, glucose, dextrose, sucrose, mannitol, yeast extract, peptone, potassium nitrate, ammonium chloride, and ammonium nitrate with 1% concentration were amended to the selected medium [31,32,33]. After the addition of carbon and nitrogen sources separately in the growth medium, all flasks were incubated at 25 ± 1 °C for 12 days and the CFCF of each broth was observed for antibacterial activity.
Determination of Optimum Incubation Temperature
The variations in temperature directly impact the growth and production of metabolites from fungi [34]. Therefore, for maximum production of antibacterial compounds, Phoma sp. D1 was incubated at different temperatures of 15 °C, 20 °C, 25 °C, 30 °C, 35 °C, and 40 °C for 12 days in an incubator (REMI, India) to determine antibacterial activity.
Determination of Optimum pH
The pH of the growth medium indirectly affects the metabolism of organisms and influences the enzymatic action of fungi. For the optimization of the pH of the medium, fermentation broth with eight different pH values, 3, 4, 5, 6, 7, 8, 9, and 10, was prepared and incubated for 12 days at 25 ± 1 °C. After incubation, the metabolite was separated using filter paper and antibacterial activity was observed against the test pathogen by the agar well diffusion method [35].
Purification of Bioactive Compounds
The purification of bioactive compounds from endophytic fungi is a crucial process. Therefore, the purification of antibacterial bioactive compounds from Phoma sp. D1 using solvent–solvent extraction and thin-layer chromatography approaches was implemented.
Solvent –Solvent Extraction of fungal metabolite
In the case of solvent–solvent extraction, antibacterial compounds were extracted with a wide range of solvents having different polarities like cyclohexane, carbon tetrachloride, ethyl acetate, toluene, benzene, and dichloromethane. Equal volumes of (1:1 v/v) of CFCF and solvents were taken in a separating funnel, shaken for 10–15 min, and kept stationary for 25–30 min. After that solvent fractions were separated successfully and evaporated solvent in sterilized condition. The remaining residue left after evaporation was mixed with dimethyl sulfoxide (DMSO) and their antibacterial activity against bacterial strain was observed. After confirmation of the solvent in which a positive result was obtained, further extraction of the compound was done in a rotary vacuum evaporator and the yielded extract was used for separation of the antibacterial compound.
Thin-Layer Chromatography (TLC)
In this method, a number of different solvent systems were tried in order to attain a good resolution for purification of the antibacterial compounds. Finally, the solvent system benzene:methanol (50:50 v/v) was further used for purification of the compound in TLC and two spots were observed on the TLC plate with different retention factor (Rf) values. The spots were scraped out separately from the TLC plate, mixed with DMSO, and centrifuged at 8000 rpm for 20 min. The collected fractions were tested for antibacterial activity by agar well diffusion.
Rf = migration distance of compound/migration distance of solvent front.
Chemical Characterization of Antibacterial Compound
In order to characterize antibacterial compounds, active fractions collected after TLC were subjected to gas chromatography–mass spectrometry (GC–MS) analysis. The sample was analyzed in an Agilent 19091 s-431u1 GCMS/MS 700 1C analyzer and introduced via an all-glass injector working in the split-less mode, with helium as the carrier gas with a linear velocity of 25.779 cm/s. An HP-5 MS UI fused silica capillary column (length: 15 m, film thickness: 250 μm, I.D.: 0.25 mm) was used. The temperature program was as follows: 60–300 °C at 40 °C/min, 170–310 °C at 10 °C/min, and a 5-min hold at 310 °C. The identification of bioactive compounds was performed by mass spectra with data from the library.
Computational Observation (DFT Evaluation)
In the present scenario, the computation observation such as DFT evaluation plays a significant role in gaining experimental date and predicts the different properties of the bioactive compounds. Therefore, in the present study, initially, all the characterized bioactive compounds were optimized and analyzed using the Gauss View 6.0.16 program, GAUSSIAN 09 suite of programs, and the most reliable theoretical method and density functional computations (DFT) were performed [36, 37]. Carbon, nitrogen, oxygen, and hydrogen atoms were primarily calculated with the help of B3LYP and exchange correlation functional with 6–31 G (d, p) basic sets.
Results
Isolation and Identification of Fungi
In the present study, a total 12 endophytic fungi were isolated from different parts of four medicinal plants collected from different sites of Jabalpur (M.P.), India. All isolated fungal strains were identified by using the slide culture technique on the basis of their morphological (Fig. 1) and microscopic characteristics. The endophytic fungi belong to different classes in the fungal family as depicted in Table 1.
Screening of Endophytic Fungi for Antibacterial Activity
In the antibacterial screening of endophytic fungi, all fungal strains were grown on PDB medium for 7, 14, and 21 days and incubated in a fungal incubator at 25 ± 1 °C. Out of 12 endophytic fungi, only two displayed maximum zones of inhibition against the test bacterial strain after 14 days of incubation period (Table 2).
The fungal strain Phoma sp. D1 isolated from Bryophyllum pinnatum (Lam.) Oken, was observed for the highest zone of inhibition against Klebsiella pneumoniae (18.25 ± 0.58 mm), Bacillus subtilis (22.75 ± 0.85 mm), Escherichia coli (19.30 ± 0.76 mm), and Staphylococcus aureus (16.30 ± 0.65 mm). Similarly, Fusarium oxysporum showed antibacterial activity against Klebsiella pneumoniae (14.00 ± 0.60 mm), Bacillus subtilis (16.35 ± 0.96 mm), Escherichia coli (18.00 ± 0.68 mm), and Staphylococcus aureus (16.50 ± 0.70 mm) respectively. The other endophytic fungi like Nigrospora sp., Fusarium solani, Aspergillus fumigatus, Monilia sp., and Fusarium moniliformi were also observed for their antibacterial activity against the pathogenic bacteria (Fig. 2).
Determination of the Optimum Medium
For the evaluation of the suitable medium for growth and production of antibacterial secondary compounds, five different media, potato dextrose (PDB) medium, Sabouraud dextrose (SDB) medium, maltose yeast extract broth (MYEB), Czapek Dox broth (CDB), and Richard broth (RB) medium (Fig. 3), were used for potent Phoma sp. D1 fungi. The SDB medium was observed for maximum production of antibacterial activity after 14 days of incubation against Klebsiella pneumoniae (19.40 ± 0.60 mm), Bacillus subtilis (23.80 ± 0.90 mm), Escherichia coli (21.40 ± 0.75 mm), and Staphylococcus aureus (18.90 ± 0.80 mm).
Determination of the Optimum Incubation Period
To find out the appropriate incubation period, Phoma sp. D1 was inoculated on SDB medium for 21 days and it showed minor antibacterial activity from the 6th day of its incubation and maximum antibacterial activity was observed on the 12th day of its incubation period against Klebsiella pneumoniae (19.45 ± 0.65 mm), Bacillus subtilis (24.35 ± 0.56 mm), Escherichia coli (21.20 ± 0.57 mm), and Staphylococcus aureus (16.90 ± 0.90 mm). After the 12th day of incubation, the activity declined continuously and stopped in the 20th day of incubation (Fig. 4).
Determination of Optimum Carbon Source
To observe the effect of carbon sources on the production of antibacterial compounds of Phoma sp. D1, the SDB medium was replaced with different carbon sources such as glucose, galactose, dextrose, maltose, and sucrose and the maximum activity was observed in the case of dextrose-supplemented medium against test bacterial strains K. pneumoniae (21.05 ± 0.68 mm), Bacillus subtilis (24.88 ± 0.70 mm), Escherichia coli (22.25 ± 0.94 mm), and Staphylococcus aureus (17.75 ± 0.55) as shown in Fig. 5.
Determination of Optimum Nitrogen Source
Similarly, to examine the effect of nitrogen sources on the production of antibacterial compounds from Phoma sp. D1, different nitrogen sources such as peptone, yeast extract, ammonium chloride, ammonium nitrate, and potassium nitrate were added in the medium and maximum antibacterial activity was observed in the case of yeast extract against bacterial strains K. pneumoniae (21.20 ± 0.75 mm), Bacillus subtilis (24.50 ± 0.77 mm), Escherichia coli (22.70 ± 0.95 mm), and Staphylococcus aureus (16.85 ± 0.80 mm) as displayed in Fig. 6.
Determination of Optimum Incubation Temperature
The fungal strain Phoma sp. D1 was incubated at different temperatures for maximum growth and antibacterial metabolite production followed by 15, 20, 25, 30, 35, and 40 °C. The maximum activity was observed at 25 ± 1 °C against K. pneumoniae (20.95 ± 0.90 mm), Bacillus subtilis (24.10 ± 0.71 mm), Escherichia coli, (23.03 ± 0.60 mm), and Staphylococcus aureus (17.06 ± 0.83 mm) as depicted in Fig. 7.
Determination of Optimum pH
The pH of the culture medium is one of the very important determining parameters for the biosynthesis of secondary metabolites, so Phoma sp. D1 was grown on pH levels 4, 5, 6, 7, 8, and 9. The maximum antibacterial activity was observed at pH 8 against Bacillus subtilis (24.50 ± 0.94 mm), Escherichia coli (22.60 ± 0.82 mm), K. pneumoniae (21.96 ± 0.64 mm), and Staphylococcus aureus (17.44 ± 0.56 mm) as displayed in Fig. 8.
Purification of Bioactive Compound
Solvent–Solvent Extraction
In the present study, the CFCF of potent endophytic fungi Phoma sp. D1 was extracted with different polarity solvents like cyclohexane, carbon tetrachloride, ethyl acetate, toluene, benzene, and dichloromethane (Fig. 9) in 1:1 (v/v) for the purification of antibacterial bioactive compounds. The entire fractions extracted with the solvents were tested for their antibacterial activity by the agar well diffusion method, and it was observed that ethyl acetate extract exhibited the maximum zone of inhibition against the bacteria Bacillus subtilis (25.10 ± 0.64 mm), Escherichia coli (22.30 ± 0.70 mm), K. pneumoniae (21.40 ± 0.77 mm), and Staphylococcus aureus (16.45 ± 0.76 mm).
Thin-Layer Chromatography (TLC)
In thin-layer chromatography, ethyl acetate extract was further purified by using the benzene:methanol solvent system. In TLC, two fractions with different Rf values of 0.25 and 0.96 were observed (Fig. 10). The fractions were tested for antibacterial activity, and the fraction with an Rf value of 0.25 exhibited antibacterial activity against K. pneumoniae (20.20 ± 0.60 mm), Bacillus subtilis (22.12 ± 0.82 mm), Escherichia coli (21.70 ± 0.90 mm), and Staphylococcus aureus (14.85 ± 0.76 mm) (Fig. 11).
Structure Elucidation of Bioactive Compounds by GC–MS/MS
The TLC fraction that exhibited antibacterial activity was subjected to GC–MS/MS for structure analysis. The sample was run counts vs. acquisition time (in min), and a number of peaks were observed with different molecular weights. The chromatogram shows the presence of one major peak in a TLC extracted spot, and some other small peaks were also found as shown in Fig. 12. A total of five compounds, 2-(-cyclohexenyl) ethylamine, 2-chloro-6 fluorophenol, butyl ether2-hydroxyskatole4-glycerol, p-coumarate, and bicyclo [1, 2, 4] nona-2,4-dien-9-one, were identified on different RT and with different % area. But the intense peak of the ESI/MS spectra was observed at RT 11.085 with transition at 147 and was identified as 2-hydroxy skatole (C9H9N) as displayed in Table 3.
Investigative Computation (DFT Studies)
The essential method for interpreting the atomic arrangements of various prepared compounds for DFT research was conducted on a GAUSSIAN platform. To theoretically establish the geometry of all compounds (Fig. 13), the B3LYP/ 6–31 + G (d, p) basic set was used to optimize the geometry of each compound. By applying the DFT/B3LYP 6–31 + G (d,p) fundamental sets, the single point energy and dipole moment (D) value of all compounds are evaluated (Table 4). It is evident from the energy values that compound 3 has a greater single point energy than the other compounds [38, 39]. Compound 5 assumes that less energy equals greater stability, based on the total energy of all the compounds. The dipole moment of compound 3 is greater than that of the other compounds. From these comparison values, it is evident that all compounds possess dipole–dipole interaction.
Frontier Molecular Orbital (FMO) Studies
The FMO studies make it easy to comprehend the reaction of the compound and predict the active site in a conjugated system. The energies of the highest occupied molecular orbitals (EHOMO) and the energies of the lowest unoccupied molecular orbitals (ELUMO) of all compounds explain the global reactivity descriptors such as chemical hardness, chemical potential, and electrophilicity. Negative EHOMO and ELUMO values for all compounds confirm their stability (Fig. 14). The electron cloud of compound 1 is localized on N26 for the active atomic sites in the position of neucleophilic attack. From the difference in bond energy, the chemical reactivity and chemical stability of the active molecule are explicable. The difference energy [EHOMO − ELUMO] for compound 5 is established to be less than the energy gap of the other compounds based on the energy difference values, which are the strongest evidence for the greater reactivity of compound 5. In contrast, compound 2 is more stable.
The FMO’s research explains the chemical reactivity of the compound and the molecular selection of its active sites. From the FMO band energy values and the energy difference between HOMO and LUMO, the charge transfer (CT) interaction is described. Few significant chemical reactivity parameters including electronegativity (χ), chemical potential (μ), global hardness (η), global softness (S), and global electrophilicity index (ω) are listed in Table 5 [40].
The EHOMO and ELUMO plots (Fig. 6) of the compounds determine the exact orbital energy gap within the mapped molecular orbitals. Few essential quantum chemical parameters, such as chemical softness (S), are lower for compound 2 than for the other compounds; consequently, the stability of compound 2 is greater than that of the other compounds. Some additional crucial parameters, such as the electrophilicity (ω) value, are assigned as positive quantities that evaluate the tendency of the system to accept electrons from its environment. Comparing all compounds, compound 2 is the most stable because its electrophilicity value is less than those of the other compounds (Table 5).
QSAR Studies
QSAR is useful for predicting the activity, reactivity, and properties of reported compounds. All computations were performed using the HyperChem Professional 8.0.3 program. The compounds’ structures were optimized using the (MM +) force field, with semi-empirical PM3 methods, and the Fletcher–Reeves conjugate gradient algorithm to minimize energy. The evaluated log P values of compound 5 are higher than those of all other compounds. The partition coefficient (log P) values play a crucial role in explaining the biological activity of synthesized compounds. Specifically, the log P is essential for measuring the permeability of the employed compound into the cell membrane. Other essential physical parameters, such as surface area, volume, hydration energy, refractivity, polarizability, mass, total energy, free energy, and RMS gradient, are also calculated to suggest the action of the compounds listed in Table 6.
Discussion
The exploration of endophytic fungi is continuously being conducted in order to isolate and characterize novel bioactive compounds against a number of ailments. Because of this, huge studies were conducted on the endophytic fungi especially associated with medicinal plants and observed that these myco-organisms present a great source of bioactive compounds. In one of the studies, the endophytic fungi Aspergillus sp., Alternaria alternata, Cladosporium sp., Diaporthe sp., Curvularia sp., Fusarium sp., Macrophomina spp., and Trichoderma spp. were isolated from various parts of Cupressus torulosa D. Don., Alstonia boonei-ahun, Enantia chlorantha-Awopa, and Kigelia africana plants [41]. The findings of this study are in agreement with a previous report in which endophytic fungi were isolated from Sceletium tortuosum L., Moringa oleifera, and Withania somnifera and their antibacterial activity against Escherichia coli and Staphylococcus aureus was observed [42, 43]. In many of the studies, it was found that the in vitro optimization of endophytic fungi on different media, temperatures, carbon and nitrogen sources, and pH levels supports the maximum production of novel bioactive compounds [44, 45]. Therefore, Deka et al. [46] observed the effect of optimization of the culture medium for maximum production of bioactive compounds on Czapeck–Dox broth (CDB), potato–dextrose broth (PDB), malt extract broth (MEB), Sabouraud dextrose broth (SDB), and V8 juice broth, and the highest fungal growth and bacterial zone of inhibition was found in potato–dextrose broth. Similarly, maximum growth and antibacterial metabolite production from Nigrospora sp. ML#3 were observed in Sabouraud dextrose broth [30]. In another research work, endophytic fungi Aspergillus sp. CPR5 and Cymbidium aloifolium were also optimized on various carbon and nitrogen for maximum production of secondary metabolites and the fungal strain [31, 47]. For biosynthesis of natural bioactive compound naphthoquinones, the endophytic fungi Fusarium solani was tested on different carbon sources, glucose, fructose, xylose, sucrose, sodium acetate, and glycerol. In the case of Altenuene synthesis from Alternaria alternata isolated from Catharanthus roseus, the fungal media were replaced with a number of nitrogen sources such as soybean meal, yeast extract, tryptone, beef extract, peptone, casein, and urea, and the best production was observed in the case of soybean meal and glycerol [48]. In the case of temperature, the fungal strain Aspergillus fumigatus strain KARVS04 was optimized in a range of 25–30 °C and a better result was obtained at 29 °C [49]. In another research work, the endophytic fungus Fusarium solani showed maximum growth and antibacterial activity at an optimized temperature of 25 °C [50]. Endophytic fungus Athelia rolfsi strain displays maximum growth of biomass at pH 5 and maximum production of antibacterial bioactive compounds from potent endophytic fungal strain Fusarium sp. DF2 was obtained at pH 6 that showed maximum zone of inhibition against Bacillus subtilis, Staphylococcus aureus, and Escherichia coli [51].
For purification and characterization of bioactive compounds from the endophytic fungi, there are many techniques being carried out like solvent–solvent extraction, thin-layer chromatography column chromatography, gas chromatography, etc. In the case of endophytic fungus Thielaviopsis basicola, the bioactive compounds were extracted through an aqueous solvent system and further purification was carried out in thin-layer chromatography by using chloroform and methanol solvent system [52]. In a previous finding, the antibacterial compounds extracted from different types of 40 endophytic fungi isolated from 10 medicinal plants were separated by using thin-layer chromatography and the activity bacterial strain [53]. In the case of endophytic fungi Colletotrichum sp. and Fusarium sp., the antibacterial compounds were also separated by thin-layer chromatography by using a mixture of hexane, ethyl acetate/hexane, ethyl acetate, and acetate/methanol [54].
The bioactive compounds isolated from the endophytic fungus Arthrinium sp. MFLUCC16-1053 were characterized by using GC–MS, and the mass spectra of the molecules were compared with library data and verified through relative peak area percentage that were related to C8–C23 n-alkanes [55]. In another study, the bioactive metabolites extracted from entophytic fungi Phoma sp. isolated from Tectona grandis L. were analyzed by GC–MS/MS and a total of eleven compounds were characterized [56]. Further, the atomic arrangements of antibacterial compounds were studied through computational analysis such as DFT and FMO which helps to find out and predict the active site in a conjugated system. Due to the advancement in the sciences and technology, various software programs like QSAR are widely used for predicting the activity, reactivity, and properties of reported compounds isolated from the endophytic fungi [40, 57]. Hence, the endophytic fungi widely exploited from plants act as a replenished source of novel bioactive compounds and have a wide range of activities. The results described in this study definitely help to scale up for bioactive molecule production and formulation of pharmaceutical products in future from the endophytic microbes.
Conclusions
The endophytic fungi are unique microorganisms for producing antibacterial secondary metabolic compounds and also have gained the attention of the scientific community because of their potential applications in the fields of agriculture and pharmaceutical industries. The result of this study substantiates the presence of antibacterial compound from the endophytic Phoma sp. D1 fungal strain isolated from the Bryophyllum pinnatum. This is easily cultured and optimized in in vitro conditions for maximum production of the antibacterial bioactive compound. From the present observation, it can be concluded that Phoma sp. D1 has potential to produce an antibacterial bioactive compound which may be used in the field of pharmacology and also as a prospective source of valuable drugs. However, further work will need to be undertaken to determine its toxicity profile, reliability, and economical value.
Data Availability
The datasets generated during and/or analyzed during the current study are available from the corresponding author on reasonable request.
References
Yassin A, AlOmari M, Al-Azzam S, Karasneh R, Abu-Ismail L, Soudah O. Impact of social media on public fear, adoption of precautionary behaviors, and compliance with health regulations during COVID-19 pandemic. Int J Environ Health Res. 2022;32(9):2027–39.
Aware CB, Patil DN, Suryawanshi SS, Mali PR, Rane MR, Gurav RG, Jadhav JP. Natural bioactive products as promising therapeutics: a review of natural product-based drug development. S Afr J Bot. 2022;19.
Visalakchi S, Muthumary J. Taxol (Anticancer drug) producing endophytic fungi: an overview. IJPBS. 2010;1:BS31.
Cragg GM, Newman DJ. Natural products a continuing source of novel drug leads. Biochimica et Biophysica Acta (BBA)-Gen Sub. 2013;1830:3670–95.
Kumar S, Aharwal RP, Shukla H, Rajak RC, Sandhu SS. Endophytic fungi: as a source of antimicrobials bioactive compounds. World J Pharma Pharm Sci. 2014;3:1179–97.
Aharwal RP, Kumar S, Sandhu SS. Endophytic mycoflora as a source of biotherapeutic compounds for disease treatment. J Appl Pharma Sci. 2016;6:242–54. https://doi.org/10.7324/JAPS.2016.601034.
Kumar S, Aharwal RP, Jain R, Sandhu SS. Bioactive molecules of endophytic fungi and their potential in anticancer drug development. Curr Pharmacol Rep. 2021;7:27–41. https://doi.org/10.1007/s40495-021-00251-y.
Rai N, Gupta P, Keshri PK, Verma A, Mishra P, Kumar D, Kumar A, Singh SK, Gautam V. Fungal endophytes: an accessible source of bioactive compounds with potential anticancer activity. Appl Biochem Biotechnol. 2022;194(7):3296–319.
Mamangkey J, Mendes LW, Harahap A, Briggs D, Kayacilar C. Endophytic bacteria and fungi from Indonesian medicinal plants with antibacterial, pathogenic antifungal and extracellular enzymes activities: a review. Int J Sci Technol Manag. 2022;3:245–55. https://doi.org/10.46729/ijstm.v3i1.428.
Singh R, Dubey AK. Endophytic actinomycetes as emerging source for therapeutic compounds. Indo Global J Pharm Sci. 2015;5:106–16. https://doi.org/10.35652/IGJPS.2015.11.
Joseph B, Priya RM. Bioactive compounds from endophytes and their potential in pharmaceutical effect: a review. Am J Biochem Mol Biol. 2011;1:291–309. https://doi.org/10.3923/ajbmb.2011.291.309.
Bogas AC, CruzFPN Lacava PT, Sousa CP. Endophytic fungi: an overview on biotechnological and agronomic potential. Braz J Biol. 2022;84:e258557. https://doi.org/10.1590/1519-6984.258557.
Aharwal RP, Kumar S, Sandhu SS. Endophytic mycoflora: antibacterial secondary metabolites and their therapeutic potential. Curr Pharmacol Rep. 2021;7:150–70. https://doi.org/10.1007/s40495-021-00261-w.
Santra HK, Maity S, Banerjee D. Production of bioactive compounds with broad spectrum bactericidal action, bio-film inhibition and antilarval potential by the secondary metabolites of the endophytic fungus Cochliobolus sp. APS1 isolated from the Indian medicinal herb Andrographispaniculata. Molecules. 2022;27:1459. https://doi.org/10.3390/molecules27051459.
Sahu R, Kumar S, Aharwal RP, Sandhu SS. Antibacterial activity of isolated endophytic fungi from Rauvolfia serpentina (L.) Benth ex Kurz. Int J Pharm Pharma Sci. 2016;8:38–42. https://doi.org/10.22159/ijpps.2016v8i11.9733.
Gupta S, Chaturvedi P, Kulkarni MG, Van Staden J. A critical review on exploiting the pharmaceutical potential of plant endophytic fungi. Biotechnol Adv. 2020;39:107462. https://doi.org/10.1016/j.biotechadv.2019.107462.
Ganie SA, Rather LJ, Li Q. Review on anti-cancer and anti-microbial applications of curdlan biomaterials. J Polym Environ. 2022;1:1–6.
Philip S, Jayasree EG, Mohanan K. Antidiabetic, antioxidant, DFT and molecular docking studies of a triazene derivative and its transition metal complexes. Res ChemIntermed. 2020;46:75–99. https://doi.org/10.1007/s11164-019-03936-8.
Bagur H, Medidi RS, Somu P, Choudhury PJ, Karua CS, Guttula PK, Melappa G, Poojari CC. Endophyte fungal isolate mediated biogenic synthesis and evaluation of biomedical applications of silver nanoparticles. Mat Tech. 2022;37:167–78. https://doi.org/10.1080/10667857.2020.1819089.
Saithong P, Panthavee W, Stonsaovapak S, Li C. Isolation and primary identification of endophytic fungi from Cephalotaxusmannii trees. Maejo Int J Sci Technol. 2010;4:446–53.
Liang H, Xing Y, Chen J, Zhang D, Guo S, Wang C. Antimicrobial activities of endophytic fungi isolated from Ophiopogonjaponicus (Liliaceae). BMC Complement Altern Med. 2012;12:1–6. https://doi.org/10.1186/1472-6882-12-238.
Marsola SJ, Jorge LF, Meniqueti AB, Bertéli MBD, de Lima TEF, Bezerra JL, Lopes AD, Gazim ZC, do Valle JS, Colauto NB, Linde GA. Endophytic fungi of Brunfelsia uniflora: isolation, cryopreservation, and determination of enzymatic and antioxidant activity. World J Microbiol Biotechnol. 2022;38:1-15. https://doi.org/10.1007/s11274-022-03278-5
Sandhu SS, Aharwal RP, Kumar S. Isolation and antibacterial property of endophytic fungi isolated from Indian medicinal plant Calotropisprocera Linn. World JPharm Pharm Sci. 2014;3:678–91.
Domsch KH, Gams W, Anderson TH. Compendium of soil fungi. Volume 1.Academic Press (London) Ltd.1980
Maadon SN, Wakid SA, Zainudin II, Rusli LS, Mohdzan MS, Hasan N, Shah NAA, Rohani ER. Isolation and identification of endophytic fungi from UiTM Reserve Forest, Negeri Sembilan. Sains Malaysiana. 2018;47:3025–30. https://doi.org/10.17576/jsm-2018-4712-12.
Rodrigo AR, Atilon VDA, Renildo MDC, Clarice MC. Antibacterial activity of endophytic fungi from the medicinal plant Uncaria tomentosa (Willd.) DC. J Med Plants Res. 2018;2:179–85. https://doi.org/10.5897/JMPR2018.6558.
Palanichamy P, Krishnamoorthy G, Kannan S, Marudhamuthu M. Bioactive potential of secondary metabolites derived from medicinal plant endophytes. Egypt J Basic Appl Sci. 2018;5:303–12. https://doi.org/10.1016/j.ejbas.2018.07.002.
Mao Z, Zhang W, Wu C, Feng H, Peng Y, Shahid H, Cui Z, DingP Shan T. Diversity and antibacterial activity of fungal endophytes from Eucalyptus exserta. BMC Microbiol. 2021;21:1–12. https://doi.org/10.1186/s12866-021-02229-8.
Mathan S, Subramanian V, Nagamony S. Optimization and antimicrobial metabolite production from endophytic fungi Aspergillus terreus KC582297. European J Exp Biol. 2013;3:138–44.
Sandey K, Aharwal RP, Kumar S, Sandhu SS. Production and optimization of antibacterial metabolites from endophytic fungi Nigrospora sp. ML# 3. J Appl Pharm Sci. 2015;5:031–7. https://doi.org/10.7324/JAPS.2015.501105.
Verma SK, Lal MOTI, Das MD. Optimization of process parameters for production of antimicrobial metabolites by an endophytic fungus Aspergillus sp Cpr5 isolated from Calotropis procera root. Optimization. 2017;10:225–30. https://doi.org/10.22159/ajpcr.2017.v10i4.16631.
Jain P, Gupta S. Effect of carbon and nitrogen sources on antimicrobial metabolite production by endophytic fungus Penicillum sp against human pathogens. J Pharma Res. 2012;5:4325–8.
Gogoi DK, Deka Boruah HP, Saikia R, Bora TC. Optimization of process parameters for improved production of bioactive metabolite by a novel endophytic fungus Fusarium sp DF2 isolated from Taxus wallichiana of North East India. World J MicrobiolBiotechnol. 2008;24:79–87. https://doi.org/10.1007/s11274-007-9442-3.
Clarance P, Khusro A, Lalitha J, Sales J, Paul A. Optimization of camptothecin production and biomass yield from endophytic fungus Fusarium solanistrain ATLOY-8. J Appl Pharm Sci. 2019;9:35–46. https://doi.org/10.7324/JAPS.2019.91005.
Kaur N, Arora DS. Prospecting the antimicrobial and antibiofilm potential of Chaetomiumglobosum an endophytic fungus from Moringaoleifera. AMB Express. 2020;10:206. https://doi.org/10.1186/s13568-020-01143-y.
Frisch MJ, Trucks GW, Schlegel HB, Scuseria GE, Robb MA, Cheeseman JR, Fox DJ. Gaussian 09, version D. 01; Gaussian. Inc., Wallingford, CT.2009.
GaussView 6.0, (Gaussian Inc., Wallingford, CT, USA) 2019.
Sarangi AK, Mahapatra BB, Sethy SK. Synthesis and characterization of tetranuclear metal complexes with an octadentate azodye ligand. Chem Afr. 2018;1:17–28. https://doi.org/10.1007/s42250-018-0002-z.
Sarangi AK, Mahapatra BB, Mohapatra RK, Sethy SK, Das D, Pintilie L, Kudrat-E-Zahan M, Azam M, Meher H. Synthesis and characterization of some binuclear metal complexes with a pentadentate azodye ligand: an experimental and theoretical study. Appl Organomet Chem. 2020;34(8):e5693. https://doi.org/10.1002/aoc.5693.
Mohapatra RK, Dhama K, El-Arabey AA, Sarangi AK, Tiwari R, Emran TB, Azam M, Al-Resayes SI, Raval MK, Seidel V, Abdalla M. Repurposing benzimidazole and benzothiazole derivatives as potential inhibitors of SARS-CoV-2:DFT, QSAR, molecular docking, molecular dynamics simulation, and in-silico pharmacokinetic and toxicity studies. J King Saud Uni Sci. 2021;33:101637. https://doi.org/10.1016/j.jksus.2021.101637.
Rajput K, Chanyal S, Agrawal PK. Optimization of protease production byendophytic fungus, Alternariaalternata isolated from gymnosperm tree-CupressustorulosaD Don. World J Pharm Pharm Sci. 2016;5:1034–54.
Manganyi MC, Regnier T, Tchatchouang CDK, Bezuidenhout CC, Ateba CN. Antibacterial activity of endophytic fungi isolated from Sceletiumtortuosum L. (Kougoed). Ann Microbiol. 2019;69:659–63. https://doi.org/10.1007/s13213019-1444-5.
Atri N, Rai N, Singh AK, Verma M, Barik S, Gautam V, Singh SK. Screening for endophytic fungi with antibacterial efficiency from Moringaoleifera and Withaniasomnifera. J Sci Res. 2020;64:127–33.
Dwibedi V, Rath SK, Prakash R, Saxena S. Response surface statistical optimization of fermentation parameters for resveratrol production by the endophytic fungus Arcopilus aureus and its tyrosinase inhibitory activity. Biotechnol Lett. 2021;43:627–44.
Santra HK, Maity S, Banerjee D. Production of bioactive compounds with broad spectrum bactericidal action, bio-film inhibition and antilarval potential by the secondary metabolites of the endophytic fungus Cochliobolus sp. APS1 isolated from the Indian medicinal herb Andrographispaniculata. Molecules. 2022;27(5):1459.
Deka D, Jha DK. Optimization of culture parameters for improved production of bioactive metabolite by endophytic Geosmithia pallida (KU693285) isolated from Brucea mollis Wall ex Kurz, an endangered medicinal plant. J Pure Appl Microbiol. 2018;12:1205–13.
Chowdappa S, Jagannath S, Konappa N, Udayashankar AC, Jogaiah S. Detection and characterization of antibacterial siderophores secreted by endophytic fungifrom Cymbidium aloifolium. Biomol. 2020;10:1412. https://doi.org/10.3390/biom10101412.
Bhagat J, Kaur A, Kaur R, Yadav AK, Sharma V, Chadha BS. Cholinesterase inhibitor (Altenuene) from an endophytic fungus Alternariaalternata: optimization, purification and characterization. J Appl Microbiol. 2016;121:1015–25. https://doi.org/10.1111/jam.13192.
Astuti P, Aryantini D, Eden WT, Wahyono W. Pharmaceutical microbiology and biotechnology cultural conditions affect the growth of endophytic fungi Aspergillus fumigatus and improve its total and bioactive metabolite production. Res J Pharm BiolChem Sci. 2017;8:1770–8.
Merlin JN, Christhudas IVSN, Kumar PP, Agastian P. Optimization of growth and bioactive metabolite production: Fusarium solani. Asian J Pharm Clin Res. 2013;6:98–103.
Yuniati L, Monica E, Rollando R. Effect of variation conditions fermentation to production biomass of endophytic fungi Atheliarolfsii Strain orchid. J Pharm Sci Res. 2018;10:2862–5.
Mane RS, Vedamurthy AB. Structure elucidation and therapeutic applications of endophytic fungi derived bioactive compounds obtained from Ximeniaamericana Western Ghats of Karnataka India. Int JPharma Sci Res. 2020;11:212–25.
Raunsai M, Wulansari D, Fathoni A, Agusta A. Antibacterial and antioxidant activities of endophytic fungi extracts of medicinal plants from Central Sulawesi. J Appl PharmaSci. 2018;8:069–74.
Jiang CX, Li J, Zhang JM, Jin XJ, Yu B, Fang JG, Wu QX. Isolation, identification, and activity evaluation of chemical constituents from soil fungus Fusarium avenaceum SF-1502 and endophytic fungus Fusarium proliferatum AF-04. J Agri Food Chem. 2019;67:1839–46. https://doi.org/10.1021/acs.jafc.8b05576.
Pansanit A, Pripdeevech P. Antibacterial secondary metabolites from an endophytic fungus, Arthriniumsp MFLUCC16–1053 isolated from Zingiber cassumunar. Mycol. 2018;9:264–72. https://doi.org/10.1080/21501203.2018.1481154.
Senthilkumar N, Murugesan S, Babu DS, Rajeshkannan C. GC-MS analysis of the extract of endophytic fungus, Phomopsis sp isolated from tropical tree species of India. Tectona grandis L IJIRSET. 2014;3:10176–9.
Abdalla M, Mohapatra RK, Sarangi AK, Mohapatra PK, Eltayb WA, Alam M, Dhama K. In silico studies on phytochemicals to combat the emerging COVID-19 infection. J Saudi Che Soc. 2021;25:101367. https://doi.org/10.1016/j.jscs.2021.101367.
Funding
The lab facilities and funding was provided by Bio Design Innovation Centre, Rani Durgavati University, Jabalpur (M.P.), India.
Author information
Authors and Affiliations
Contributions
We declare that this work was done by the authors named in this article and the authors will bear all liabilities about claims relating to the content of this article.
Corresponding author
Ethics declarations
Competing interests
The authors declare no competing interests.
Conflict of Interest
No conflict of interest associated with this work.
Additional information
Publisher's Note
Springer Nature remains neutral with regard to jurisdictional claims in published maps and institutional affiliations.
Rights and permissions
Springer Nature or its licensor (e.g. a society or other partner) holds exclusive rights to this article under a publishing agreement with the author(s) or other rightsholder(s); author self-archiving of the accepted manuscript version of this article is solely governed by the terms of such publishing agreement and applicable law.
About this article
Cite this article
Kumar, S., Aharwal, R.P., Singh, D. et al. Isolation and Chemical Structural Elucidation of Antibacterial Bioactive Compounds from Endophytic Fungal Strain Phoma sp. D1. Curr Pharmacol Rep 9, 128–143 (2023). https://doi.org/10.1007/s40495-023-00317-z
Accepted:
Published:
Issue Date:
DOI: https://doi.org/10.1007/s40495-023-00317-z